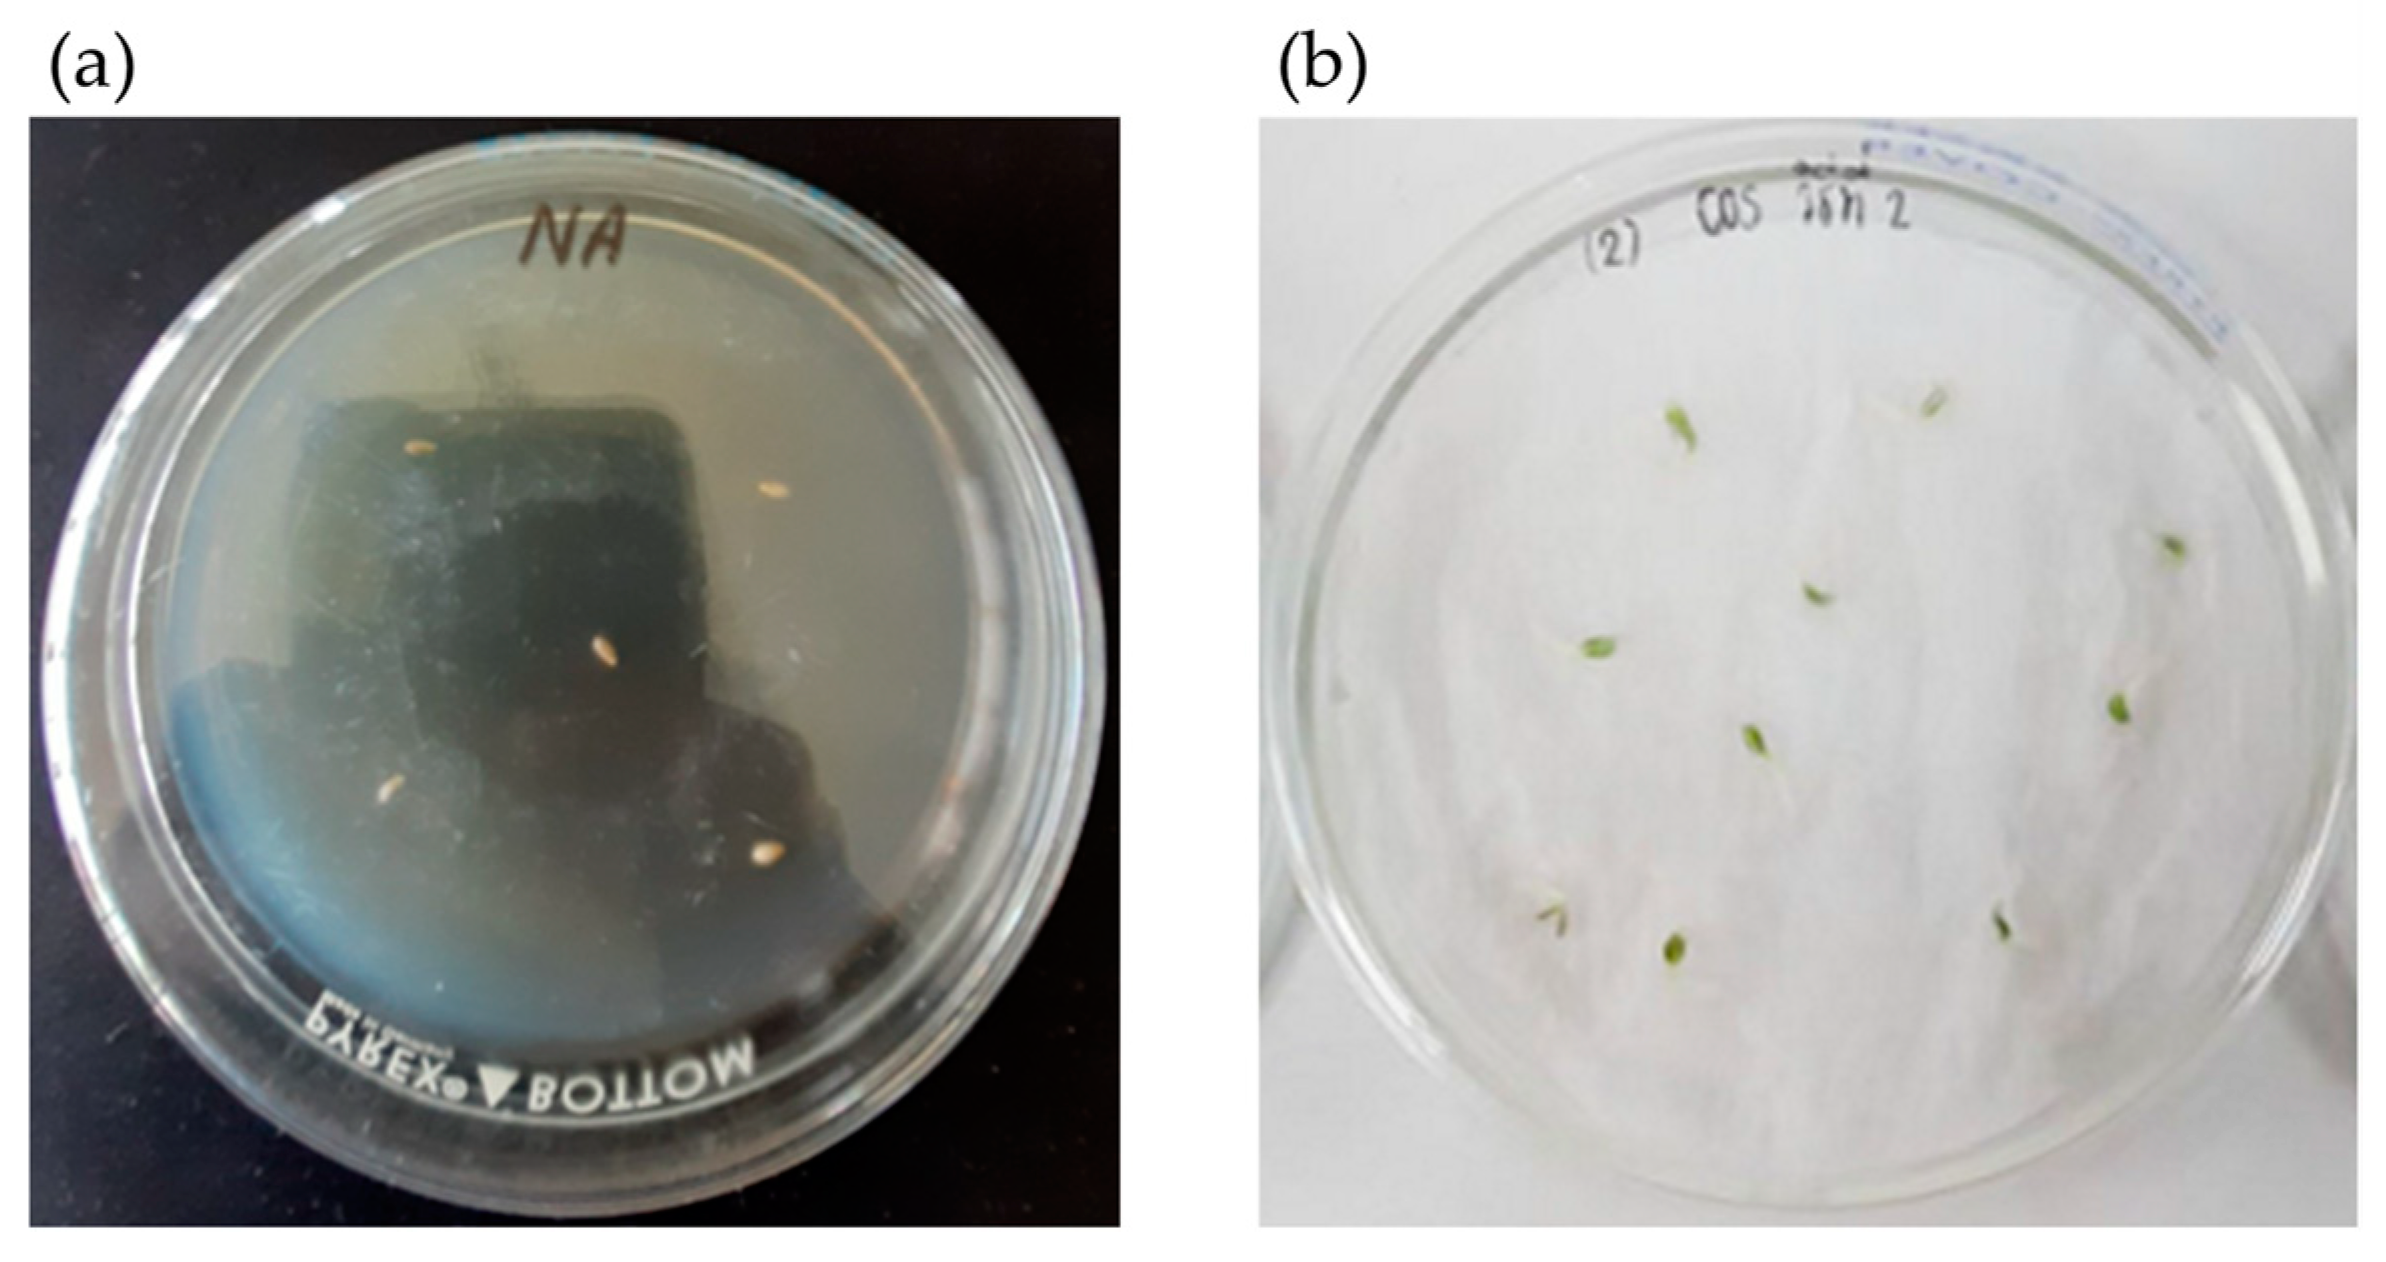
Plants 12 03793 g002

Employing a Plant Probiotic Actinomycete for Growth Promotion of Lettuce (Lactuca sativa L. var. longifolia) Cultivated in a Hydroponic System under Nutrient Limitation
Abstract
:1. Introduction
2. Materials and Methods
2.1. Microorganism and Spore Preparation
2.2. Inoculant Preparation
2.3. Experimental Design
2.4. Analytical Methods
2.5. Statistical Analysis
3. Results
4. Discussion
5. Conclusions
Supplementary Materials
Author Contributions
Funding
Data Availability Statement
Acknowledgments
Conflicts of Interest
References
- Ahmed, Z.F.; Alnuaimi, A.K.; Askri, A.; Tzortzakis, N. Evaluation of lettuce (Lactuca sativa L.) production under hydroponic system: Nutrient solution derived from fish waste vs. Inorganic nutrient solution. Horticulturae 2021, 7, 292. [Google Scholar] [CrossRef]
- Sapkota, S.; Sapkota, S.; Liu, Z. Effects of nutrient composition and lettuce cultivar on crop production in hydroponic culture. Horticulturae 2019, 5, 72. [Google Scholar] [CrossRef]
- Majid, M.; Khan, J.N.; Shah, Q.M.A.; Masoodi, K.Z.; Afroza, B.; Parvaze, S. Evaluation of hydroponic systems for the cultivation of lettuce (Lactuca sativa L., var. Longifolia) and comparison with protected soil-based cultivation. Agric. Water Manag. 2021, 245, 106572. [Google Scholar] [CrossRef]
- Spehia, R.S.; Devi, M.; Singh, J.; Sharma, S.; Negi, A.; Singh, S.; Chauhan, N.; Sharma, D.; Sharma, J.C. Lettuce growth and yield in hoagland solution with an organic concoction. Int. J. Veg. Sci. 2018, 24, 557–566. [Google Scholar] [CrossRef]
- Sebring, R.L.; Duiker, S.W.; Berghage, R.D.; Regan, J.M.; Lambert, J.D.; Bryant, R.B. Gluconacetobacter diazotrophicus inoculation of two lettuce cultivars affects leaf and root growth under hydroponic conditions. Appl. Sci. 2022, 12, 1585. [Google Scholar] [CrossRef]
- Moncada, A.; Vetrano, F.; Miceli, A. Alleviation of salt stress by plant growth-promoting bacteria in hydroponic leaf lettuce. Agronomy 2020, 10, 1523. [Google Scholar] [CrossRef]
- de Souza, P.F.; Borghezan, M.; Zappelini, J.; de Carvalho, L.R.; Ree, J.; Barcelos-Oliveira, J.L.; Pescador, R. Physiological differences of ‘Crocantela’ lettuce cultivated in conventional and hydroponic systems. Hortic. Bras. 2019, 37, 101–105. [Google Scholar] [CrossRef]
- Bakhshian, M.; Naderi, M.R.; Javanmard, H.R.; Bahreininejad, B. The growth of summer savory (Satureja hortensis) affected by fertilization and plant growth regulators in temperature stress. Biocatal. Agric. Biotechnol. 2022, 43, 102371. [Google Scholar] [CrossRef]
- Irshad, M.K.; Ibrahim, M.; Noman, A.; Shang, J.; Mahmood, A.; Mubashir, M.; Khoo, K.S.; Ng, H.S.; Show, P.L. Elucidating the impact of goethite-modified biochar on arsenic mobility, bioaccumulation in paddy rice (Oryza sativa L.) along with soil enzyme activities. Process Saf. Environ. Prot. 2022, 160, 958–967. [Google Scholar] [CrossRef]
- Fatima, B.; Bibi, F.; Ali, M.I.; Woods, J.; Ahmad, M.; Mubashir, M.; Khan, M.S.; Bokhari, A.; Khoo, K.S. Accompanying effects of sewage sludge and pine needle biochar with selected organic additives on the soil and plant variables. Waste Manag. 2022, 153, 197–208. [Google Scholar] [CrossRef]
- Yakkou, L.; Houida, S.; Bilen, S.; Kaya, L.O.; Raouane, M.; Amghar, S.; El Harti, A. Assessment of earthworm (Aporrectodea molleri)’s coelomic fluid-associated bacteria on different plant growth-promoting traits and maize germination and seedling growth. Biocatal. Agric. Biotechnol. 2022, 42, 102341. [Google Scholar] [CrossRef]
- Autarmat, S.; Treesubsuntorn, C.; Thiravetyan, P. Comparison of using plant growth promoting bacteria and exogenous indole acetic acid on rice under ozone stress. Biocatal. Agric. Biotechnol. 2023, 48, 102633. [Google Scholar] [CrossRef]
- Toan, N.S.; Nguyen, T.D.P.; Thu, T.T.N.; Lim, D.T.; Dong, P.D.; Gia, N.T.; Khoo, K.S.; Chew, K.W.; Show, P.L. Soil mineralization as effects of plant growth promoting bacteria isolated from microalgae in wastewater and rice straw application in a long-term paddy rice in Central Viet Nam. Environ. Technol. Innov. 2021, 24, 101982. [Google Scholar] [CrossRef]
- Lasudee, K.; Tokuyama, S.; Lumyong, S.; Pathom-Aree, W. Actinobacteria associated with arbuscular mycorrhizal Funneliformis mosseae spores, taxonomic characterization and their beneficial traits to plants: Evidence obtained from mung bean (Vigna radiata) and Thai jasmine rice (Oryza sativa). Front. Microbiol. 2018, 9, 1247. [Google Scholar] [CrossRef]
- Omar, A.F.; Abdelmageed, A.H.; Al-Turki, A.; Abdelhameid, N.M.; Sayyed, R.Z.; Rehan, M. Exploring the plant growth-promotion of four Streptomyces strains from rhizosphere soil to enhance cucumber growth and yield. Plants 2022, 11, 3316. [Google Scholar] [CrossRef]
- Rangseekaew, P.; Barros-Rodríguez, A.; Pathom-Aree, W.; Manzanera, M. Deep-sea actinobacteria mitigate salinity stress in tomato seedlings and their biosafety testing. Plants 2021, 10, 1687. [Google Scholar] [CrossRef]
- Rangseekaew, P.; Barros-Rodríguez, A.; Pathom-Aree, W.; Manzanera, M. Plant beneficial deep-sea actinobacterium, Dermacoccus abyssi MT1. 1T promote growth of tomato (Solanum lycopersicum) under salinity stress. Biology 2022, 11, 191. [Google Scholar] [CrossRef]
- Devi, S.; Sharma, M.; Manhas, R.K. Investigating the plant growth promoting and biocontrol potentiality of endophytic Streptomyces SP. SP5 against early blight in Solanum lycopersicum seedlings. BMC Microbiol. 2022, 22, 285. [Google Scholar] [CrossRef]
- Ayuso-Calles, M.; García-Estévez, I.; Jiménez-Gómez, A.; Flores-Félix, J.D.; Escribano-Bailón, M.T.; Rivas, R. Rhizobium laguerreae improves productivity and phenolic compound content of lettuce (Lactuca sativa L.) under saline stress conditions. Foods 2020, 9, 1166. [Google Scholar] [CrossRef]
- Arnon, D. Copper enzymes in isolated chloroplasts polyphenoloxidase in Beta vulgaris. Plant Physiol. 1949, 24, 1–16. [Google Scholar] [CrossRef]
- Velikova, V.; Yordanov, I.; Edreva, A.J.P.S. Oxidative stress and some antioxidant systems in acid rain-treated bean plants: Protective role of exogenous polyamines. Plant Sci. 2000, 151, 59–66. [Google Scholar] [CrossRef]
- Chromkaew, Y. Phenotypic and Genotypic Characterization of Endophytic Actinomycetes Isolated from Tangerines and Their Potential for Plant Growth Promotion. Master’s Thesis, Department of Soil Science, Chiang Mai University, Chiang Mai, Tailand, 2009. [Google Scholar] [CrossRef]
- Chaiharn, M.; Theantana, T.; Pathom-Aree, W. Evaluation of biocontrol activities of Streptomyces spp. against rice blast disease fungi. Pathogens 2020, 9, 126. [Google Scholar] [CrossRef] [PubMed]
- Bonaldi, M.; Chen, X.; Kunova, A.; Pizzatti, C.; Saracchi, M.; Cortesi, P. Colonization of lettuce rhizosphere and roots by tagged Streptomyces. Front. Microbiol. 2015, 6, 25. [Google Scholar] [CrossRef] [PubMed]
- Chen, X.; Pizzatti, C.; Bonaldi, M.; Saracchi, M.; Erlacher, A.; Kunova, A.; Berg, G.; Cortesi, P. Biological control of lettuce drop and host plant colonization by rhizospheric and endophytic streptomycetes. Front. Microbiol. 2016, 7, 714. [Google Scholar] [CrossRef]
- Kramer-Walter, K.R.; Laughlin, D.C. Root nutrient concentration and biomass allocation are more plastic than morphological traits in response to nutrient limitation. Plant Soil 2017, 416, 539–550. [Google Scholar] [CrossRef]
- Oldroyd, G.E.; Leyser, O. A plant’s diet, surviving in a variable nutrient environment. Science 2020, 368, 6486. [Google Scholar] [CrossRef]
- Bellegarde, F.; Gojon, A.; Martin, A. Signals and players in the transcriptional regulation of root responses by local and systemic N signaling in Arabidopsis thaliana. J. Exp. Bot. 2017, 68, 2553–2565. [Google Scholar] [CrossRef]
- Zhang, H.; Zhao, Q.; Wang, Z.; Wang, L.; Li, X.; Fan, Z.; Zhang, Y.; Li, J.; Gao, X.; Shi, J.; et al. Effects of nitrogen fertilizer on photosynthetic characteristics, biomass, and yield of wheat under different shading conditions. Agronomy 2021, 11, 1989. [Google Scholar] [CrossRef]
- Wu, Y.W.; Qiang, L.I.; Rong, J.I.N.; Wei, C.H.E.N.; Liu, X.L.; Kong, F.L.; Ke, Y.P.; Shi, H.C.; Yuan, J.C. Effect of low-nitrogen stress on photosynthesis and chlorophyll fluorescence characteristics of maize cultivars with different low-nitrogen tolerances. J. Integr. Agric. 2019, 18, 1246–1256. [Google Scholar] [CrossRef]
- Becker, C.; Urlić, B.; Jukić Špika, M.; Kläring, H.P.; Krumbein, A.; Baldermann, S.; Goreta Ban, S.; Perica, S.; Schwarz, D. Nitrogen limited red and green leaf lettuce accumulate flavonoid glycosides, caffeic acid derivatives, and sucrose while losing chlorophylls, β-carotene and xanthophylls. PLoS ONE 2015, 10, e0142867. [Google Scholar] [CrossRef]
- Chen, S.; Zhao, H.; Zou, C.; Li, Y.; Chen, Y.; Wang, Z.; Jiang, Y.; Liu, A.; Zhao, P.; Wang, M.; et al. Combined inoculation with multiple arbuscular mycorrhizal fungi improves growth, nutrient uptake and photosynthesis in cucumber seedlings. Front. Microbiol. 2017, 8, 2516. [Google Scholar] [CrossRef] [PubMed]
- Santos, M.S.; Nogueira, M.A.; Hungria, M. Microbial inoculants: Reviewing the past, discussing the present and previewing an outstanding future for the use of beneficial bacteria in agriculture. AMB Express 2019, 9, 205. [Google Scholar] [CrossRef] [PubMed]
- Kudoyarova, G.; Arkhipova, T.; Korshunova, T.; Bakaeva, M.; Loginov, O.; Dodd, I.C. Phytohormone mediation of interactions between plants and non-symbiotic growth promoting bacteria under edaphic stresses. Front. Plant Sci. 2019, 10, 1368. [Google Scholar] [CrossRef]
- Reis, M.N.O.; Vitorino, L.C.; Lourenço, L.L.; Bessa, L.A. Microbial inoculation improves growth, nutritional and physiological aspects of Glycine max (L.) Merr. Microorganisms 2022, 10, 1386. [Google Scholar] [CrossRef] [PubMed]
- Nieves-Cordones, M.; López-Delacalle, M.; Ródenas, R.; Martínez, V.; Rubio, F.; Rivero, R.M. Critical responses to nutrient deprivation: A comprehensive review on the role of ROS and RNS. Environ. Exp. Bot. 2019, 161, 74–85. [Google Scholar] [CrossRef]
- Tan, F.; Cheng, J.; Zhang, Y.; Jiang, X.; Liu, Y. Genomics analysis and degradation characteristics of lignin by Streptomyces thermocarboxydus strain DF3-3. Biotechnol. Biofuels Bioprod. 2022, 15, 78. [Google Scholar] [CrossRef]
- Qin, X.; Xin, Y.; Su, X.; Wang, X.; Wang, Y.; Zhang, J.; Tu, T.; Yao, B.; Luo, H.; Huang, H. Efficient degradation of zearalenone by dye-decolorizing peroxidase from Streptomyces thermocarboxydus combining catalytic properties of manganese peroxidase and laccase. Toxins 2021, 13, 602. [Google Scholar] [CrossRef]
- Islam, F.; Yasmeen, T.; Arif, M.S.; Ali, S.; Ali, B.; Hameed, S.; Zhou, W. Plant growth promoting bacteria confer salt tolerance in Vigna radiata by up-regulating antioxidant defense and biological soil fertility. Plant Growth Regul. 2016, 80, 23–36. [Google Scholar] [CrossRef]

| Parameters | Full-Strength Nutrient Solution | Half-Strength Nutrient Solution | ||
|---|---|---|---|---|
| Uninoculated Lettuce | Inoculated Lettuce | Uninoculated Lettuce | Inoculated Lettuce | |
| Number of leaves | 12.25 ± 0.50 b | 13.75 ± 0.50 a | 11.25 ± 0.50 c | 12.75 ± 0.50 b |
| Fresh weight (g) | 52.01 ± 6.00 a | 52.86 ± 2.23 a | 23.12 ± 2.12 c | 34.11 ± 2.30 b |
| Dry weight (g) | 2.33 ± 0.73 a | 2.27 ± 0.06 a | 1.53 ± 0.12 b | 1.92 ± 0.12 ab |
| Root length (cm) | 33.10 ± 2.63 b | 36.38 ± 3.59 ab | 37.48 ± 1.78 ab | 39.75 ± 5.79 a |
| Shoot length (cm) | 25.70 ± 0.77 a | 25.98 ± 1.15 a | 17.18 ± 0.39 c | 21.45 ± 1.05 b |
| Chlorophyll a (mg/g) | 0.1329 ± 0.0169 c | 0.1715 ± 0.0465 bc | 0.1895 ± 0.0489 ab | 0.2348 ± 0.0250 a |
| Chlorophyll b (mg/g) | 0.1096 ± 0.0183 b | 0.1182 ± 0.0226 b | 0.1227 ± 0.0399 b | 0.2089 ± 0.0563 a |
| Total chlorophyll (mg/g) | 0.3646 ± 0.0343 b | 0.4450 ± 0.1040 b | 0.4829 ± 1318 b | 0.6608 ± 0.0976 a |
| Carotenoids (mg/g) | 0.2493 ± 0.0890 a | 0.2625 ± 0.0339 a | 0.1025 ± 0.0112 b | 0.1157 ± 0.0036 b |
| H2O2 (mM/g) | 1515.63 ± 640.91 c | 1528.13 ± 220.41 c | 6650.00 ± 460.19 a | 4428.13 ± 325.54 b |
Disclaimer/Publisher’s Note: The statements, opinions and data contained in all publications are solely those of the individual author(s) and contributor(s) and not of MDPI and/or the editor(s). MDPI and/or the editor(s) disclaim responsibility for any injury to people or property resulting from any ideas, methods, instructions or products referred to in the content. |
© 2023 by the authors. Licensee MDPI, Basel, Switzerland. This article is an open access article distributed under the terms and conditions of the Creative Commons Attribution (CC BY) license (https://creativecommons.org/licenses/by/4.0/).
Share and Cite
Kitwetch, B.; Rangseekaew, P.; Chromkaew, Y.; Pathom-Aree, W.; Srinuanpan, S. Employing a Plant Probiotic Actinomycete for Growth Promotion of Lettuce (Lactuca sativa L. var. longifolia) Cultivated in a Hydroponic System under Nutrient Limitation. Plants 2023, 12, 3793. https://doi.org/10.3390/plants12223793
Kitwetch B, Rangseekaew P, Chromkaew Y, Pathom-Aree W, Srinuanpan S. Employing a Plant Probiotic Actinomycete for Growth Promotion of Lettuce (Lactuca sativa L. var. longifolia) Cultivated in a Hydroponic System under Nutrient Limitation. Plants. 2023; 12(22):3793. https://doi.org/10.3390/plants12223793
Chicago/Turabian StyleKitwetch, Benyapa, Pharada Rangseekaew, Yupa Chromkaew, Wasu Pathom-Aree, and Sirasit Srinuanpan. 2023. "Employing a Plant Probiotic Actinomycete for Growth Promotion of Lettuce (Lactuca sativa L. var. longifolia) Cultivated in a Hydroponic System under Nutrient Limitation" Plants 12, no. 22: 3793. https://doi.org/10.3390/plants12223793
APA StyleKitwetch, B., Rangseekaew, P., Chromkaew, Y., Pathom-Aree, W., & Srinuanpan, S. (2023). Employing a Plant Probiotic Actinomycete for Growth Promotion of Lettuce (Lactuca sativa L. var. longifolia) Cultivated in a Hydroponic System under Nutrient Limitation. Plants, 12(22), 3793. https://doi.org/10.3390/plants12223793

